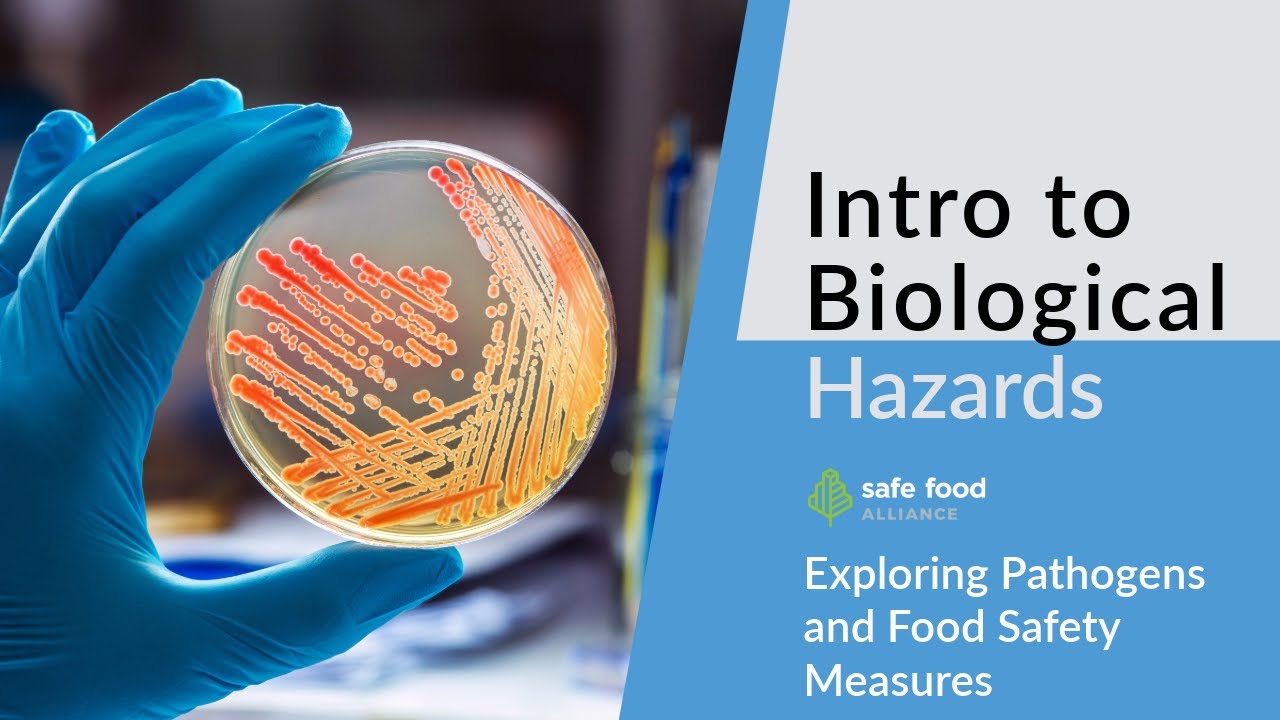
HACCP 101: Exploring Pathogens and Food Safety Measures

Welcome to the responsible training food handler safety course lesson one food safety basics introduction in this lesson you'll learn more about the importance of food safety how foods become unsafe time temperature control for safety or tcs foods major food allergens Your role as a food handler and the role of management the importance of food safety think about a restaurant where you recently ate or worked was the hot food hot and the cold food cold did the server have clean hands was there soap and paper towels in the bathroom was there trash on the floors the
table's equipment encounters clean Any place where food is prepared and served to the public must follow certain food handling practices and be kept clean why because a person can become sick if they eat food that was not handled and prepared the right way the public also includes your friends and family so food safety is important to everyone food safety is important to everyone Whether you work in a restaurant grocery store or any other type of food establishment the place where you work has to be kept clean and well maintained this creates a safe environment for
preparing and serving food why is food safety important to you because unsafe food practices can affect your health as well as the health of those you are serving to the public Because no one should worry about getting sick from going out to eat to your customers because it's their health and safety at risk to your fellow workers because it protects their jobs and their safety to your employers because a clean safe environment helps them stay in business please note Food prepared at home or in an unlicensed food establishment cannot be sold to the public without
prior approval by your local health department how foods become unsafe clean is not the same as safe hands can look clean but can be contaminated with microorganisms that cause foodborne illness food may look and smell good but the germs present could make it unsafe to eat This is why all food workers must learn how to prevent illness with safe food preparation and service these safe habits will keep you and your customers healthy you can't always see or smell that food is contaminated that's why it is very important to avoid the conditions that can make food
unsafe view each section below for more information about food dangers contamination Contamination occurs when food contains bacteria parasites viruses or other microorganisms that grow and produce natural poisons chemicals such as cleaners and insecticides or foreign objects such as glass or bits of packaging accidentally mixed into food cost of foodborne illness loss of customers and revenue loss of business reputation Lawsuits which include costs and negative publicity reduced employee productivity medical costs for pain and suffering employee absences and costs for retraining employees cross contamination when microorganisms spread between food surfaces or equipment it's most likely to happen
when raw food touches or drips onto other food Raw food touches or drips onto equipment or surfaces unclean utensils glassware or dishware are used unclean work surfaces are used or cooked food is touched with unwashed hands foodborne disease outbreak incident in which two or more people experience the same illness after eating the same food disease-causing microorganisms are Responsible for the majority of food-borne disease outbreaks foodborne illness an illness resulting from eating contaminated food foodborne illness is caused by microorganisms natural toxins or chemicals food contaminated with microorganisms or natural toxins does not look smell or taste
different from uncontaminated food symptoms vary and may include diarrhea Vomiting fever cramping and nausea depending on the cause symptoms may develop in a few minutes to several days symptoms lasting several days can result in death time temperature control for safety or tcs foods all foods should be handled safely but some have a greater risk of causing illness Time temperature control for safety or tcs foods are foods that require time and or temperature control to limit the rapid growth of bacteria pay special attention to these foods fresh eggs and egg products dairy products tofu packaged soy
protein foods meat and poultry fish and shellfish cooked beans rice and potatoes Cooked vegetables oils containing herbs garlic or other flavorings sprouts and cut fruit and vegetables such as melons tomatoes and lettuce major food allergens each year millions of people in the united states have allergic reactions to food most food allergies cause minor symptoms however some food allergies can cause Severe even life-threatening reactions around 90 percent of serious food allergies are caused by contact with the proteins in these eight foods milk eggs fish shellfish tree nuts wheat peanuts or soy beans food manufacturers must clearly
identify Any major food allergens on food labels when serving a guest with a disclosed food allergy follow the steps below refer the guest food allergy concerns to the person in charge manager or chef review the food allergy with the guest and check ingredient labels and menu items remember to check for cross contact during food preparation Cross contact is when the protein of a possible food allergen comes in contact with another food cross contact can happen when using the same cooking oil utensils cutting boards food containers gloves fryers or grills for different food items respond to
the guests and inform them of your findings if a guest has an allergic reaction Notify the management and call 911 immediately your role as a food handler you must recognize and prevent situations that can lead to foodborne illness the five major causes of foodborne illness are poor personal hygiene using contaminated equipment not reaching the final cooking temperature Using food from unsafe sources and not keeping food at the right temperature the activities that prevent food borne illness are following hand washing instructions working only when healthy storing and handling a food and a way to prevent contamination
cooking raw food to its required final cooking temperature and keeping hot food hot and cold food Cold always ask your manager if you are unsure about the safety of a food service activity lesson one quiz you have reached the end of lesson one food safety basics take time to confirm what you have learned using the lesson quiz this quiz features five multiple choice questions and you will have the opportunity to see the correct answer Lesson 2 personal hygiene introduction in this lesson you'll learn more about why personal hygiene is important how and when to wash
your hands the right way the importance of personal grooming the proper use of gloves hand sanitizers and aprons clothing and jewelry restrictions and when to wear hair restraints Start to food safety food safety begins with maintaining high standards of personal hygiene and cleanliness a food handler's lack of personal hygiene can cause food to become contaminated and may result in customers becoming ill customers prefer to eat at places where employees practice good hygiene and put food safety first put yourself in the consumer's place and Observe your co-workers food handling practices would you want to eat here
personal hygiene means keeping yourself clean and healthy the human body carries germs that can contaminate the food that customers eat or surfaces they touch by practicing the personal hygiene habits taught in this section you can protect yourself from being the cause of foodborne illness Good personal hygiene is not only important to your customers and your employer it's the law introduction washing your hands well is one of the most important parts of employee hygiene it sounds too easy but hand washing really works to wash away germs not washing your hands correctly can increase the spread of
infectious diseases causing people to become sick Hand washing is one of the most important steps in food safety and is required by law click each tab to review the times you must wash your hands when to wash your hands before an activity wash your hands before going on duty before you touch anything used to prepare food before putting on gloves Before touching utensils that will touch food before touching foods that will not be cooked when to wash your hands after an activity wash your hands after handling raw food especially meats fish and poultry after handling
eggs after touching your face hair or any other part of your body After handling trash and taking out the garbage after handling dirty dishes after cleaning or using other toxic substances double wash rule after using the restroom or after just going into the restroom you must wash your hands in the restroom and then again upon returning to the kitchen before handling food this is called the double wash rule Think and then use the sink the previous hand washing lists are not the only times to wash your hands knowing when to wash requires common sense on
your part did you shake hands with the customer did you handle money then wash your hands proper hand washing your kitchen should have a hand washing sink with warm water soap and paper towels Make sure to always wash your hands at a hand washing sink and not at a food preparation sink germs such as bacteria and viruses grow easily so think of your hands and fingernails as always contaminated just because they look clean does not mean that they are clean germs are too tiny to see with your eyes if you do not wash your hands
in the right way and if you do not keep your fingernails trimmed short your hands can Transfer germs to food which gets eaten by your customers they may get sick from these germs this is called foodborne illness or food poisoning remember soap and hot water will wash away germs if the water is not hot or hand washing supplies are not available tell your supervisor immediately how to wash your hands wet your hands and forearms with warm Running water and apply soap spend at least 20 seconds total time washing your hands rub your hands together scrubbing
hands and forearms for a minimum of 10 to 15 seconds use a nail brush to clean thoroughly under your fingernails scrubbing your nails as necessary for your hands to be clean rinse your hands and forearms completely under warm running water Dry your hands thoroughly with a single-use towel paper or cloth roll or an air dryer do not use a shared towel if washing your hands in the restroom use a clean paper towel to open the door if needed don't touch the door handle or you may recontaminate your hands do not use hand lotion it may
allow bacteria to grow single-use gloves can also spread germs Wash your hands before putting on gloves and change gloves between tasks such as switching from handling one type of food to another if your gloves become torn or overly soiled make sure to wash your hands before donning a new pair remember to always wash your hands gloves and aprons gloves and sanitizers do not replace hand washing gloves and aprons are important Protective articles that you will use working in a food establishment here's how to use them correctly wash hands and expose portion of your arms first
before putting on gloves wash hands and expose portions of your arms before applying a hand sanitizer when gloves are damaged or when you change tasks take off the old gloves wash your hands and arms and put on fresh gloves take off your apron before leaving the Kitchen or food preparation area change to a fresh apron if it gets dirty wash your hands after touching your apron change to a fresh apron or fresh pair of gloves if they get dirty bare hand contact infected food employees are the source of contamination and more than two-thirds of the
reported foodborne disease outbreaks most of these outbreaks were caused by Employees who failed to properly wash their hands after using the restroom diseases can spread to food because of poor hand washing infected cuts burns or boils on hands can also cause food to become unsafe food regulations require two methods of preventing the spread of foodborne disease not allowing workers to prepare food when they are infectious And thorough and frequent hand washing avoid touching ready to eat or rte foods with your bare hands ready to eat foods are ones that require no further cooking to be
served use utensils such as spatulas tongs wax paper or single-use gloves anything else must be approved by your manager in the health department preventing contamination food employees are allowed to contact rte food with their bare hands if the Establishment does not serve a highly susceptible population and the following requirements are met step 1 training food workers must acknowledge receiving training on the following proper hand washing when and where to wash proper fingernail maintenance the risks of bare hand contact good hygienic practices employee health policies Jewelry prohibition double hand washing nail brushing hand antiseptic after washing
incentive programs and other methods approved by the regulatory authority how to comply signed statements kept at the food establishment step 2 control measures food workers must use two or More control measures including double hand washing nail brushing hand antiseptic after washing or other methods approved by the regulatory authority how to comply written plan kept at the food establishment step 3 corrective actions how to Comply written records of who what when where and how corrections are made personal grooming take care of how you look and act you want to look clean and be clean when you're
at work your clothes must be clean and your apron or uniform should be fresh keep your hair clean and neat for your safety wear it close to your head tied back and in a net or under a hat Bathe yourself every day especially work days wear clean clothes to work daily keep hair clean and under control use a hair restraint if necessary keep fingernails clean and short it is recommended that you do not wear nail polish or false fingernails which may contaminate food if you do wear fingernail polish your hands must be covered with a
single use glove when working with food The only jewelry you are allowed to wear in food preparation areas is a plain ring such as a wedding band bracelets and other types of rings may hold dirt or bacteria that could come into contact with food jewelry can cause injury if it gets caught in equipment do not use cosmetics or perfume or cologne around foods as they may contaminate food and change your clothes if they become Dirty personal behaviors while working food service personnel must not eat drink or smoke in any food preparation or storage areas smoke
eat or drink only in designated areas smoke only in areas where there is no risk of contaminating food do not smoke or chew tobacco while you are working or when you are near food or dishwashing areas Do not eat chew gum or use tobacco products on duty use them only in assigned break areas after you smoke wash your hands before you return to work do not sit or lean on countertops tables equipment or other surfaces where food is prepared or served need to cough or sneeze step away from food utensils and or equipment Cough or
sneeze into the crook of your elbow you may also cough or sneeze into your shoulder or cover your mouth and nose with a tissue or your hand after coughing or sneezing properly wash your hands personal food and drink items are not allowed in food preparation areas apart from beverages that are in a closed container designed to prevent contamination of the employee's hands Exposed food clean equipment and the container itself most establishments and health departments discourage having beverages in the food preparation area for safety's sake the best practice is to keep food and drink limited to
designated break areas for those employees working in an area where there is excessive heat such as the grill area and if your employer allows it Use a container with a lid and straw on the cook line use a container with a lid straw and handle note most health departments require beverage containers and food preparation areas to be designed to prevent contamination of the food handler's hands this typically means a non-breakable container with a lid and straw be sure to check with your local health department to learn what kind of Beverage containers are permitted restricted areas
animals food employees may not handle or care for animals while on duty animals are not permitted on the restaurant premises with the exception of support animals for the disabled and police patrol dogs when necessary for work purposes this exception also applies to food service employees who require use of a Support animal it is also acceptable for employees to take care of fish or molluscan shellfish in display tanks when returning to food handling the employee must properly wash his or her hands if you are providing food or water to an animal in a patio or outdoor
sitting area make sure to use a single service item other Only employees who are on duty and assigned to the operation of the kitchen are allowed in the food preparation storage or dishwashing areas it is management's responsibility to exclude visitors from entering the kitchen except in cases where a supervised brief visit or tour is given doors to food preparation areas should be self-closing never leave them propped open delivery drivers repair persons and Pesticide applicators are are in compliance with this code children are not permitted in food preparation storage or dishwashing areas small hands carry germs
and busy kitchens can be dangerous lesson two quiz you have reached the end of lesson 2 personal hygiene take time to confirm what you have learned using the lesson quiz this quiz features seven multiple choice Questions and you will have the opportunity to see the correct answer lesson three receiving and storing food introduction in this lesson you'll learn more about the importance of inspecting foods before accepting delivery and what to look for when inspecting food deliveries food deliveries you want all the food in your store or Restaurant to be healthy and safe right from the
start in order for food to remain safe it has to arrive safe the receiving station is your first last and only chance to catch unsafe food before it ends up in your kitchen before accepting delivery look at the storage area of the delivery truck is it clean reject products past their expiration date Reject products that it will expire before they can be used look for signs of spoilage look for signs of physical contamination watch for damaged or previously opened containers measure food temperatures by pressing a thermometer against the item packaging and reject foods that are
not at their correct temperature besides the risk of foodborne illness accepting unsafe food is costly to your Employer who will be stuck paying for something that has to be thrown out note also look for large ice crystals on frozen food as this is a sign that the food has thawed and re-frozen keeping delivered food safe use food that comes from sources that are approved by the health department that is the law look for usda on meats look for pasteurized on milk Look for certification tags on packages of shellfish and save the shell stock tags for
90 days discard dead shellfish or shell stock with badly broken shells canned food fresh foods egg and dairy products must come from companies brokers or dairies that have been licensed and inspected ready to eat foods need to be inspected as fresh foods would ready to eat food is any food that is Edible without further washing or cooking it includes washed fruit and vegetables deli meats and bakery items remember that properly cooked food items are also considered ready to eat even if it is a tcs food good food needs good storage maintain a clean uncluttered and
well-lit delivery station move delivered foods immediately to proper storage Don't let them sit in the temperature danger zone which is 41 degrees to 135 degrees fahrenheit tell your supervisor if you feel too rushed to make an adequate inspection food must be delivered in a smooth washable container that can be easily cleaned everything in its place every food should have a proper place store each food at the proper Temperature if you take food out to use it return it properly to its correct place store food in clean wrappers or securely close containers do not store foods
on the floor or against walls avoid overloading shelves in the refrigerator store raw foods below ready-to-eat foods in fact keep them as far apart as possible if there is not enough room in the Refrigerator to cool a tcs food move some of the food that is already cold into a separate refrigerator if possible arrange foods so that the product that came in first is used first this is known as fifo or first in first out keep storage areas racks trays and carts clean and dry in dry storage keep products away from sunlight pipes and refrigeration
lines Onions and other strong smelling foods should be kept away from eggs and dairy products whole shell eggs can be stored at a maximum temperature of 45 degrees fahrenheit they are the egg seption liquid eggs should always be refrigerated refrigerate dry goods once they are mixed with liquids certain ready-to-eat foods like fresh Fruit do not need to be refrigerated the food in the refrigerator is required to be kept at 41 degrees fahrenheit or colder this helps keep food safe by slowing the growth of bacteria inspecting meats when inspecting beef accept it if it is a
bright red color a temperature of 41 degrees fahrenheit or lower firm texture that springs back to the Touch reject the beef if it is a bad color with brown or green looking purple blotches green white or black spots bad texture then sticky slimy or dry an objectionable smell damaged or dirty packaging when inspecting shipments of pork accept the shipment if it the pork is pink and lean color with white fat A temperature of 41 degrees fahrenheit or lower a firm texture that springs back to the touch reject the pork if it is a bad color
with brown or green looking purple blotches green white or black spots bad texture sticky slimy or dry an objectionable smell damaged or dirty packaging When inspecting shipments of lamb except the lamb if it is a light red color a temperature of 41 degrees or lower firm texture that springs back to the touch reject the shipment of lamb if it is a bad color with brown or green looking purple blotches green white or black spots a bad texture than sticky slimy or dry An objectionable smell and damaged or dirty packaging when inspecting shipments of poultry accept
the shipment if the poultry has a temperature of 41 degrees fahrenheit or lower fresh even coloration firm springy texture reject the shipment of poultry if it is purple or green color greenish discoloration at the neck dark wing tips Soft texture stickiness under the wings and joints an objectionable smell damaged or dirty packaging inspecting produce fresh fruits and vegetables should not show signs of mold spoilage or insects to prevent bruising or contamination avoid squeezing or handling produce whenever possible inspecting dairy when inspecting milk you should check For a pasteurized label grade a that is within the
expiration date and it is in clean undamaged packaging when inspecting cheese make sure that the rind or the wax wrapping packaging is clean and intact has an acceptable flavor and texture when inspecting butter make sure that it has no objectionable Smell and that there is no presence of mold or dirt inspecting egg products what to check for when inspecting shell eggs that they are delivered refrigerated that they are immediately placed in refrigerated equipment that maintains food at 45 degrees fahrenheit or less that the shells are clean and unbroken free of cracks or chips That they
are grade double a or grade a and the cartons display a u.s department of agriculture or usda logo what to check for when inspecting shipments of liquid eggs that the temperature is 41 degrees fahrenheit or lower that they are within the expiration date that the packaging is intact what to check for with frozen eggs temperature of zero degrees fahrenheit or lower That they are within the expiration date and the packaging is intact what to check for with inspecting shipments of dry eggs that they're within the expiration date that the packaging is intact inspecting seafood when
receiving a delivery of fish accept it if the temperature is 41 degrees fahrenheit or lower it is packed in self-draining ice it has a fresh odor and not fishy It has clear bright eyes and it has firm textured flesh that is springy to the touch reject the fish if the gills are dry and gray or grayish green if it has cloudy sunken eyes or red bordered eyes if it has soft flesh that does not spring back when touched or if there is an objectionable ammonia-like smell when receiving a shipment of lobster Accept it if the
temperature is 41 degrees fahrenheit or lower for live product or zero degrees fahrenheit for frozen if it is alive at delivery and it has hard heavy shells on the lobsters reject the shipment if the shells are soft or if there is a strong objectionable smell when receiving a shipment of shellfish Accept it if the temperature is 41 degrees fahrenheit or lower for live product or zero degrees fahrenheit for frozen product the shells are tightly closed the product is alive and it is shipped with shell stock tag containing delivery information reject the shellfish if the shells
are open and will not close when tapped this is a sign that the clam or oyster Is dead if there is a strong objectionable smell or if it is missing shell stock tags inspecting packaged goods when inspecting a shipment of frozen foods accept the shipment if it is received at a temperature of 0 degrees fahrenheit or below ice cream should be received at a temperature of 6 to 10 degrees fahrenheit reject the shipment of frozen foods for Cartons that are misshapen or damaged or if the product is surrounded by large ice crystals and cartons containing
fluid or frozen liquid when inspecting shipments of modified atmosphere packaged food accept it if it is received at the correct temperature as listed on the package reject the shipment of modified atmosphere packaged food For flawed or damaged packaging or if it is product is beyond the expiration date when inspecting shipments of canned goods accept them if they are undamaged cans with no signs of dents or swelling reject the shipment of canned goods for cans that are missing labels or are covered in rust if the cans have swelled tops or bottoms if the can has leaks
or if the can has denser flaws Especially on the seams when inspecting shipments of vacuum sealed foods accept the shipment if it is received at the correct temperature as listed on the package reject the shipment of vacuum sealed foods for flawed or damaged packaging or if the product is beyond its expiration date when inspecting shipments of dry goods accept it if there are no visible signs of damage to the packaging Reject shipments of dry goods that have torn damp or damaged packaging or if it is an insect infested product self-service areas to avoid cross-contamination take
used plates from customers coming back for seconds and give them clean plates instead the only items that can be reused in a self-service area are beverage cups make sure that food guards are in place to protect food from people sneezing or Coughing immediately replace utensils that have been dropped touched or coughed on also replace any food that has come into contact with those utensils between uses on the serving line utensils used for dispensing food can be placed directly in the food with the handle sticking out monitor temperatures of foods and hot and cold holding single
service items Styrofoam cups plastic utensils and other items meant to be thrown away after one use are considered single service items they should be stored unopened and off the floor wash your hands before unwrapping single service items to avoid contamination in the dining area avoid touching anything that will come into contact with the customer's mouth Hold cups by the bottom of the handle not the rim hold plates underneath or on the edges not with fingers extending onto the rim hold utensils by the handle not the eating end use a non-breakable utensil with a handle not
a cup or bowl to scoop ice for water glasses use tongs to serve finger foods such as breads do not reuse breads sauces or other Unwrapped or prepared foods that have been served to customers additionally community dipping containers can spread foodborne illness it's a good idea to give each customer their own container for dipping in fact the state of california requires this lesson three quiz you have reached the end of lesson three receiving and storing food take time to confirm what you have Learned using the lesson quiz this quiz features four multiple choice questions and
you will have the opportunity to see the correct answer lesson four the danger zone introduction in this lesson you'll learn more about how bacteria grow most quickly in the temperature range between 41 degrees fahrenheit and 135 degrees fahrenheit known as the danger zone how to hold foods at the proper Temperature the different kinds of thermometers and how and when to measure temperature the danger zone to be prepared cooked and served food must enter that temperature range between 41 degrees and 135 degrees fahrenheit this is where bacteria grow the best remember the time limit for food
in the danger zone is four hours After that throw it out your job is to practice safe food handling prevent cross-contamination from other sources limit the amount of time food must spend in the danger zone food that isn't being prepared or served should be stored properly start with utensils and surfaces that have been cleaned and sanitized when you're done using them clean and Sanitize them again prepare food in small amounts called batch cooking this is when you prepare only as much as you can use in four hours or less measure and record food temperatures regularly
prepare food as close as you can to the time it will be served make sure to store it properly if you are working ahead use utensils to avoid touching raw food Whenever possible your hands after each task such as when you've been working with raw meat of any kind taking out the garbage or cleaning and avoid touching food after it has been prepared for service food safely quick thawing method place the wrapped food in the prep sink under cold running water for no more than two hours afterwards clean and sanitize the sink and anything else
the water may have Touched never thaw foods on the counter at room temperature that's the danger zone slow thawing method place the tightly wrapped frozen item such as a roast on the lowest rack of the refrigerator leave room around it for air to circulate depending on size slow thawing may take up to three days This is the safest method for thawing foods cooking method some foods such as meat patties or seafood are small enough to go straight into cooking while still frozen other foods have to be thawed microwave thawing method thaw food in a microwave
oven only if it will then be cooked immediately a matter of degrees temperature is the most important factor to prepare food in A safe way thermometers are used constantly in restaurants to measure the temperature of delivered foods internal temperatures when cooking temperatures of food during reheating temperature of food during cooling cold holding and hot holding of foods food handlers must keep track of how long food stays in the danger zone between 41 degrees and 135 degrees fahrenheit This is the temperature range when microorganisms can grow quickly and possibly lead to a foodborne illness regularly check
temperatures of food that is being held if cooked food stays in the danger zone for longer than four hours throw it out that goes for meats vegetables eggs dairy cooked beans and rice or foods containing these ingredients food safety a matter of degrees Continued refrigeration is out if all refrigeration in the establishment is out or not holding temperature food service should cease measure food temperatures with a metal stem thermometer if they are 41 degrees fahrenheit or colder move foods immediately to another fridge if available if not keep its door shut when the power comes back
on measure the Food temperature again if foods have moved into the danger zone throw them out stove or oven stops working use approved methods to cool food that was cooking and refrigerate it if cooked food in a defective hot holding station falls below 135 degrees fahrenheit throw it out hot water is off no hot water equals no sanitation stop Food service immediately major service interruptions when facing issues with water sewer power or heating the best course is to close the restaurant until these essential services are restored the right tools buy metallic stemmed thermometers a probe
thermometer that is used to measure internal temperatures of food insert the lower third of its pointed metal stem into the food and read the Circular gauge at the top this thermometer should never be left in food that is cooking in an oven microwave or on a stove also note that by metallic stem thermometers are slower than probe type thermometers and report an average temperature range instead of a more accurate temperature reported at the tip therefore health inspectors generally prefer that you use another probe type thermometer Thermocouple measures temperature electronically by inserting its probe into the
food and reading its digital display probe thermometers must be small tipped time temperature indicator it looks like a label on a food package this thermometer contains liquid crystals that change color if it reaches an unsafe temperature indicating whether the food has been in the danger zone Digital thermometers measure temperature by inserting the pointed metal tip into the food and reading the digital display on the handle food specific thermometers use this device to measure just one type of food meat deep fried foods candy etc and no other equipment thermometers measure temperature in ovens Refrigeration equipment holding
carts and other cooking storage or servicing equipment place refrigerator thermometers in a place where they are easy to read note never use a mercury based thermometer or a glass thermometer to measure foods they could break and contaminate what you're measuring thermometer maintenance you need to calibrate thermometers every Day to make sure you're getting an accurate reading always calibrate a probe thermometer after it has been bumped or dropped thermometers must be cleaned and sanitized after each use to calibrate a bi-metal stem thermometer first place the probe in a clean container of half ice half water make
sure that the tip doesn't touch the bottom or edge of the container and second 30 seconds after the gauge needle stops moving turn the calibration nut located just below the gauge until the needle reads 32 degrees fahrenheit this method doesn't always work for thermocouples and digital thermometers if they require adjustment try replacing the battery if that doesn't work tell your manager the stem of the thermometer must be cleaned and sanitized before and after Use never insert a dirty thermometer into food temperature logs your kitchen maintains a temperature logging system for tracking foods in the danger
zone use it to record the temperature of the food the time that that temperature is taken and anything unusual for instance if chilled foods rise above 41 degrees fahrenheit after logging it inform your manager promptly correct readings probe thermometers are primarily used to measure the internal temperature of food for most measurements let the needle or readout stabilize for at least 15 seconds avoid touching the sensor probe against the sides or bottom of a container which may be a different temperature than the Food and give a false reading foods while cooking insert the sensor device into
the center of the food and take a measurement in at least two places make sure the stem of the thermometer doesn't touch bone which can give the wrong temperature small liquid containers open one container a half pint of cream for example in the batch and insert your thermometer If the contents of that container can't be used immediately throw it away soft flexible bulk containers fold the container back on itself with the thermometer nestled in the fold taking care not to penetrate the material frozen packages stack two frozen packages with the thermometer placed in between times
and temperatures the following chart shows the minimum Internal cooking times and temperatures never serve undercooked poultry or pork follow these guidelines to kill germs while cooking for turkey chicken and wild game the minimum internal cooking temperature is 165 degrees fahrenheit for at least one second for ground beef ground pork eggs that will not be consumed right away An injected or mechanically tenderized meat the minimum internal cooking temperature is 155 degrees fahrenheit for at least 17 seconds for whole intact beef whole pork seafood and eggs that will be consumed right away the minimum internal cooking temperature
is 145 degrees fahrenheit for at least 15 seconds Raw animal foods that are cooked in a microwave must be cooked to a minimum internal temperature of 165 degrees fahrenheit covered rotated or stirred and allowed to stand for two minutes after cooking serving hot and cold foods food is sometimes served or stored in hot holding or cold holding stations this is equipment that is designed to control temperature When working with these holding stations bring food to the holding station in a covered container use long handled utensils instead of your hands to stir or move food utensils
should be kept in the food with the handle pointing away from the food when not in use or else placed in a container with drinkable running water keep containers covered whenever possible stir the food frequently to maintain Even temperature and avoid hot or cold spots measure food temperatures by looking at the thermometer placed in the food not just by reading the holding station's thermostat containers used in serving situations like salad bars and delis must be cleaned and sanitized at least every 24 hours note do not mix new food with the old Instead remove the container
holding the old food and replace it with the container holding the new food holding foods holding cold foods for cold holding do not let food stand at room temperature because that will allow germs to grow store foods in a refrigerator refrigerated display case in ice or other approved method always hold cold foods at 41 degrees Fahrenheit or less fish shellfish poultry milk and red meat will stay safe longer if you cold hold them at or below 40 degrees fahrenheit use the metal stem thermometer to check food in salad bars and in coolers if you use
ice to keep food cold on a salad bar or food display be sure that the ice comes up to the level of the food that is in the pan or the dish food must be colder than 41 degrees Fahrenheit when you put it in the ice cold food is held at 41 degrees fahrenheit or lower to keep germs from growing it should be measured for temperature using a probe thermometer at least every four hours make sure that the holding unit's lighting is far enough away from the food to keep it from heating it don't mix
new food with old holding hot Foods preheat hot holding stations such as steam tables soup warmers crock pots and other heated surfaces before placing food in them hot food is kept at 135 degrees fahrenheit or higher and should be measured for temperature in more than one place using a metal stem thermometer at least every two hours make sure it stays at the correct temperature throughout your shift hot food must be at 135 degrees Fahrenheit or above before placing it in a hot holding unit after placing food on a steam table stir regularly to avoid cold
spots if leftover food is reheated for hot holding it must reach an internal temperature of 165 degrees fahrenheit and all parts of the food before being placed in the steam table cooling foods hot food that can't be served within Four hours should be cooled and placed in refrigerated storage state law requires that foods be chilled from 135 degrees fahrenheit to 70 degrees fahrenheit within 2 hours and then dropped from 70 degrees fahrenheit to 41 degrees fahrenheit within four additional hours in other words hot foods must pass through the danger zone within a total of six
hours to be considered safe Cut it up cut large food items like cooked meats into smaller portions place them in a covered container and then place in the refrigerator make sure you allow cooked foods to cool to near room temperature before covering them and placing them in the refrigerator shallow pans pour thick foods such as sauces and stews into pre-chilled pans to a depth Of no more than two inches place the pans in the top rack of the refrigerator stirring regularly until chilled to 41 degrees fahrenheit or colder and then cover ice water bath chill
pots of hot food such as soup by placing the pot in a larger container and surrounding the pot with ice stir the food frequently so that it chills evenly to 41 degrees fahrenheit or colder Blast chiller place the pan of food in a blast chiller if your workplace has one once food is cooled move it to a larger covered storage container note never place a large pot of hot food in the refrigerator it will raise the temperature inside the fridge into the danger zone and the food in the pot will not cool quickly enough allowing
large amounts of bacteria to Grow hot and prepared foods if food does not cool from 135 degrees fahrenheit to 70 degrees fahrenheit within two hours and from 70 degrees fahrenheit to 41 degrees fahrenheit within an additional four hours don't save it throw it out foods that do cool properly and are ready for refrigeration should be labeled listing the contents as well as The date and time prepared food that is cooked and then cooled may need to be heated again when you must reheat food do it very quickly within one hour of dropping below 135 degrees
fahrenheit to 165 degrees fahrenheit the right way to do this is on the stove burners or in microwave ovens convection ovens or double boilers do not use anything that will slowly Heat food because it may spend too much time in the danger zone stir the food to be sure that all parts of it are hot then use your metal stem thermometer to check the temperature reheat all previously cooked foods to 165 degrees fahrenheit reheating food reheat food only once using the stovetop grill or oven never use hot holding equipment which cannot reheat food effectively enough
to Kill microorganisms the reheated food should reach a temperature of at least 165 degrees fahrenheit for a minimum of 15 seconds do not mix reheated food with fresh food if food cannot be reheated within two hours throw it out check the temperature of reheated food with the metal stem thermometer before serving lesson four quiz you have reached the end of lesson four The danger zone take time to confirm what you have learned using the lesson quiz this quiz features five multiple choice questions and you will have the opportunity to see the correct answer lesson five
sanitation cleaning and maintenance introduction in this lesson you'll learn more about the difference between cleaning and sanitizing When to clean or sanitize how to use different cleaning and sanitizing tools how to clean surfaces and equipment and the correct way to handle spills cleaning burst sanitizing it takes more than soap and water to keep a food business clean and safe it also takes chemicals and care to use them the right way you want to be safe and you want to get the job done in a safe way for your Customers some of the chemicals you will
need are detergents and sanitizers these help stop germs from spreading cleaning cleaning removes dirt debris stains and spills use hot water detergent scrubbing and wiping implements and clean water for rinsing sanitizing sanitizing is the process of reducing The number of microorganisms by using heat or chemicals on a clean surface dishes and equipment are sanitized to reduce bacteria to safe levels to be effective cleaning and sanitizing must be done in the correct order surfaces must first be cleaned and then rinsed before being sanitized sanitizing kills the microorganisms on a surface either with very hot water or
a chemical solution The correct way to manually clean dishes and utensils is pre-scrape wash rinse sanitize and then air dry the three sink process before you can sanitize you must always first wash and rinse manual cleaning and sanitizing uses a three sink process as follows sink one after pre-scraping and rinsing dishes And utensils wash them in the first sink containing hot water and detergent the water temperature must be a minimum of 110 degrees fahrenheit sink two rinse the clean dishes under clean hot water sink 3. sanitize the dishes using a chemical solution chlorine based sanitizer
should be 50 to 100 parts per million or ppm Concentration quaternary ammonium sanitizers are the most common in the food service industry and are usually 100 to 150 ppm concentration submerge dishes in 75 to 120 degrees fahrenheit sanitizing solution for at least 30 seconds alternatively immersion in hot water can be used to sanitize dishes as long as the temperature of the water is at least 171 degrees fahrenheit and dishes remain Submerged for at least 30 seconds no chemical sanitizer is required if the hot water immersion method is used drying set the items in a strainer
to air dry do not use a towel for drying the two sink process a three compartment sink may not always be practical you may find two compartment sinks in small kitchens with limited space for example A mobile food truck may use only two sinks for washing dishes you must limit the number of items that are washed at one time if you are using a two compartment sink and sanitizing solutions must be made right before you begin and drained right after you finish approval must be given by your local health authority before a two compartment sink
can be used in a food establishment there is more than one way to correctly Clean and sanitize dishes using a two compartment sink so check with your manager or local health authority if you are uncertain about the procedure you are using sink one after pre-scraping dishes and utensils wash and rinse them in the first sink containing hot water and detergent the water temperature must be a minimum of 110 degrees fahrenheit sink to Sanitize the dishes using a chemical solution or immersion in hot water chlorine-based sanitizer should be 50 to 100 parts per million concentration quaternary
ammonium sanitizers are the most common in food service and are usually 100 to 150 ppm concentration if using chemical sanitizers submerge dishes in 75 degrees to 120 degrees fahrenheit sanitizing solution for at least 30 seconds alternatively Immersion in hot water can be used to sanitize dishes as long as the temperature of the water is at least 171 degrees fahrenheit and dishes remain submerged for at least 30 seconds no chemical sanitizer is required if the hot water immersion method is used drying set the items in a strainer to air dry do not use a towel for
drying using the dishwasher a mechanical dishwasher can use Chemicals to sanitize or heats water to sanitizing temperature utensils and surfaces that come into contact with raw meat knives and cutting boards for example should always go through the dishwasher place rinsed scraped and pre-soaked dishes and utensils in the racks so that all sides will be cleaned and excess water will drain away run the machine according to manufacturers directions Dishwashers that do not use chemical sanitizers can heat water up to 194 degrees fahrenheit for the sanitizing rinse but not less than 165 degrees fahrenheit for stationary rack
single temperature dishwashers or 180 degrees fahrenheit for all other types of mechanical dishwashers temperatures of 195 degrees fahrenheit and above can bake food particles onto dishes and utensils machines that use Chemical sanitizers operate at lower temperatures usually around 120 degrees fahrenheit and use chlorine or other chemicals injected into the final rinse even though machines are considered automatic their efficiency depends on the person operating the machine allow dishes to air dry drying agents may be used to speed up this process but they must be fda Approved information about manual cleaning cleaning equipment scrub rinse and sanitize
cutting boards knives and other utensils after each task to avoid cross-contamination wash rinse with clear clean water and then sanitize slicers and food processors after each task cleaning electrical equipment and utensils unplug first Wash equipment surfaces with soapy water rinse with clean clear water and then sanitize with the chemical bleach solution after each task take out removable parts cleaning and sanitizing each one before setting them aside to air dry reassemble the equipment washing and sanitizing surfaces that you touch testing and using sanitizing solutions use special test strips to measure the strength of your sanitizing solution
For bleach chlorine solutions the test strip should turn blue that indicates a 50 to 100 parts per million concentration of chlorine which is ideal for proper strength to kill germs less than 50 parts per million is too weak more than 100 parts per million is too strong and could make people sick note sanitizing solutions will not adequately Kill germs when they are dirty or diluted even if they smell strong mix up a fresh solution and then test it for strength using wiping cloths use separate wiping cloths for cleaning surfaces that come into contact with food
such as equipment prep tables or cutting boards or do not come into contact with food such as floors walls or countertops each type of wiping cloth is stored in Its own separate bucket containing sanitizing solution wiping cloths that are in use should be stored in a sanitizer solution between uses always use a fresh or sanitized cloth for each cleanup task cleaning and storage cleaning up spills spills on the floor are a workplace hazard that must be cleaned up immediately Make sure to read your company policy for cleaning up after sick people tell people to avoid
the area of the spill use a mop and bucket containing the correct cleaning solution follow the directions for proper use and remove any remaining moisture post warning signs or cones to divert floor traffic until the spill side is dry put cleaning supplies away properly and Wash hands before returning to work chemical storage cleaners and other non-food items are always stored separately from foods by using separate shelves cupboards and sometimes even separate rooms never store food in chemical containers and never store chemicals in food containers chemicals should be kept in their original packaging or in other
unbreakable clearly labeled containers When using chemicals follow the handling instructions contained in the safety data sheets sds that should be available in your workplace chemicals should be kept away from food handling areas if chemicals come into contact with food throw the food away store chemicals below and away from food and utensils clean up all spills immediately then wash your hands If needed change into fresh clothes pest controlling garbage you don't store garbage inside the establishment you move it promptly out of the food handling area to the waste container outside make sure that doors and external
windows keep out pests such as flies and rats you should not allow food or other waste to gather In food areas keep the storage area clean arrange for garbage to be removed regularly close garbage containers with a tight fitting lid the use of pesticides and food establishments is restricted only licensed pest control personnel are allowed to use them pesticides are not allowed to be stored in a food establishment proper disposal of garbage Place garbage in sturdy leak-proof containers plastic or metal with tight fitting lids the container should be lined with clear plastic bags or with
wet strength paper clean and sanitize garbage containers frequently to prevent odor and keep from attracting insects and other pests after any kind of garbage duty wash your hands mobile and temporary food establishments while mobile food establishments are Operated almost exclusively by those with a food manager certification it is possible for a food handler to work in a temporary food establishment such as a festival or fair mobile and temporary food establishments still require the same level of caution and safety as any food establishment and fall under the same laws as a brick and mortar establishment if
you are working in a temporary food establishment make sure to check with Management regarding any special procedures that are allowed such as using a two compartment sink lesson 5 quiz you have reached the end of lesson five sanitation cleaning and maintenance take time to confirm what you have learned using the lesson quiz this quiz features seven multiple choice questions and you will have the opportunity to see the correct answer lesson six Employee health status introduction in this lesson you'll learn more about injuries on the job when to work and when not to work food borne
illnesses and how to handle minor cuts and burns sick call reporting employee health you must tell the person in charge if you think you may be sick don't be a hero Contact your supervisor to call in sick if you have fever or chills vomiting or nausea diarrhea jaundice heavy coughing and sneezing or a runny nose sore throat with fever eye discharge an infected cut or burn open wounds or boils Working when you are sick can make others sick if you have an open cutter wound regardless of whether or not it is infected you may still
handle food if the wound is covered with a water resistant bandage and a glove note if your supervisor clears you for work but you're taking medication store it in your locker are another safe place away from food Public health foodborne illness has a big effect on public health reportable foodborne illnesses the following illnesses are the big six they must be reported to the health department by your manager non-typhoidal salmonella typhoid fever caused by salmonella typhi shigella e coli o157h7 Hepatitis a virus norovirus in addition to the pathogens listed above entamoeba histolytica is another serious foodborne
illness in fact the state of california requires cases of entamoeba histolytica to be reported to the health department to protect against the transmission of these serious foodborne illnesses to the customers or fellow workers You must be excluded until cleared by a physician to return to food service work excluded or restricted you must be excluded from a food establishment if a doctor diagnoses you with one of the big six illnesses and you have symptoms of the illness excluded equals cannot go to work restricted duties there may be times when you can still go to work but
not work with food for example if you have allergies Restricted equals cannot work with food your manager will decide if you can work or not treating injuries inform your supervisor of any injuries if an infection has not occurred you may be reassigned to a job that doesn't involve food handling for example working with money you can tell when an injury is infected because it will be inflamed read around The wound or have pus if you receive a minor burn you should apply cool running water to the affected area do not handle food if you have
an uncovered infected cut burn or sore if the injury is not infected or is properly covered with a waterproof bandage and glove you may be cleared to handle food you must wash your hands keep the injury clean and bandaged and wear gloves or Other covering over the affected area first aid supplies should be stored in a kit or container and located in an area that prevents contamination of food lesson 6 quiz you have reached the end of lesson 6 employee health status take time to confirm what you have learned using the lesson quiz this quiz
features four multiple choice questions and you will have the opportunity to see the correct answer You